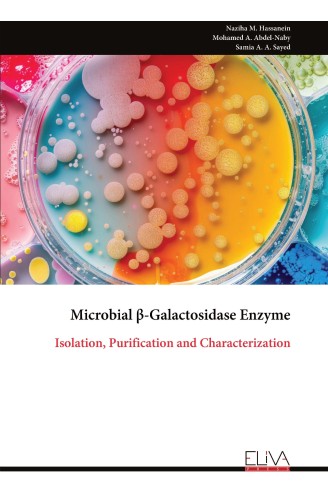

Microbial β-Galactosidase Enzyme
$ 75
Description
This book includs isolation and identification of some bacterial strains for the production of beta galactosidase enzyme (β-gal). Selection of the most potent strain through testing different microbial cultures to produce extracellular β-gal. Investigation of some fermentation parameters to maximize enzyme production by the selected strain using one variable at a time (OVAT) and statistical factorial design. Partial purification and stabilization of β-gal by applying chemical modification and immobilization techniques. Characterization of the three forms of β-gal (free, modified, and immobilized). Evaluation of thermal stability, kinetic and thermodynamic parameters of native, immobilized and modified enzymes. Study the transgalactosilation reaction of partial pure β-gal and synthesis of galacto-oligosaccharides (GOS). Evaluation the prebiotic and anti-oxidant activities of the produced GOS using immobilized β-gal.



